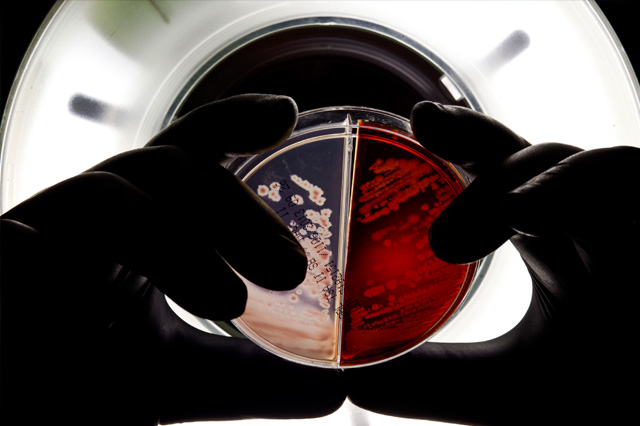

全自动微生物划线接种工作站
全自动微生物划线接种工作站是一台应用于批量接种平板培养皿的自动化设备,它支持2小时无人值守,取代 繁琐的手工接种,全自动完成平板划线/涂布流程,提供快速、标准化的细菌接种结果。
技术指标
设备技术参数
| 设备尺寸 | L*W*H 2250mm*1550mm*2500mm |
| 重量 | 650kg(含生物安全柜) |
| 工作台高度 | 900mm |
| 单次培养基加载数量 | 210个 |
| 最大加载样本数 | 200管max |
| 接种环 | 2个接种环 |
| 培养皿类型 | 90mm平板培养皿 |
| 单次样本处理时间 | ~45s |
| 机械臂负载能力 | 3KG |
| 机械臂精度 | ±0.02mm |
| 净化效率 | 100级(美国联邦标准209E) |
| 消毒方式 | 紫外线/75%酒精喷洒 |
| 防护等级 | 满足IP20,局部IP65 |
| 额定功耗 | 3KW |
| 供电电源 | 220VAC 50HZ |

工作流程

产品特点
- 130个平皿/小时
- 兼容尿、痰等多种样本
- 最大210个平板储存
- 最快45s完成一个样本